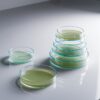

At Bargains. we specialize in providing a comprehensive range of high-quality laboratory consumables and equipment to meet the diverse needs of scientific research and medical professionals. Our extensive inventory includes various types of pipettes such as micropipettes. multichannel pipettes. volumetric pipettes. serological pipettes. automatic pipettes. electronic pipettes. positive displacement pipettes. repeater pipettes. and leading brands like Eppendorf. Gilson. Sartorius. Biohit. Integra. Rainin. and Finnpipette. as well as accessories like pipette tips. pipette fillers. and wide bore tips. We offer essential laboratory items like petri dishes. agar plates. and cryogenic storage solutions. including cryovials and cryoboxes. alongside parafilm materials and tape to ensure proper sealing and sample integrity. Our collection features specialized dropper bottles in glass. plastic. and amber varieties. with options for wholesale orders. Additionally. we stock tincture bottles. transfer pipettes. graduated pipettes. Pasteur pipettes. and mL and mL Falcon tubes to support precision handling of liquids. For cutting-edge laboratories. we provide advanced tools such as the Eppendorf Research Plus. Xplorer. and Multipette systems. Integra multichannel pipettes. and Drummond pipet aids. Whether you need plastic or glass dropper bottles. agar dishes. or pipette aids. Bargains is your trusted supplier for all your laboratory needs. delivering exceptional quality and reliability for scientific success.
glass petri dish
R55.00 Ex VAT
. We take pride in offering an extensive range of laboratory consumables and equipment to meet the exacting standards of researchers and healthcare professionals. Our collection includes micropipettes. multichannel pipettes. volumetric pipettes. and positive displacement pipettes. with brands like Sartorius. Eppendorf. Integra. and Rainin. Accessories like pipette tips. pipette fillers. and wide bore tips complete the selection. Key lab items such as petri dishes. cryovials. cryoboxes. agar plates. and parafilm tape are readily available. Additionally. we supply dropper bottles. Falcon tubes. tincture bottles. and Pasteur pipettes. Advanced tools like the Eppendorf Multipette. Research Plus. and Xplorer systems provide cutting-edge solutions for your lab. Rely on us for dependable laboratory supplies.